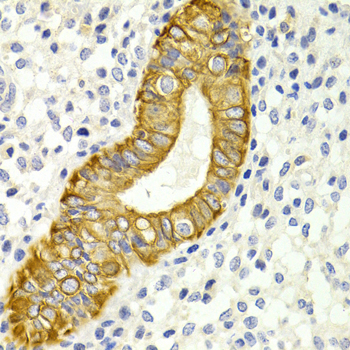
A2894: image 3
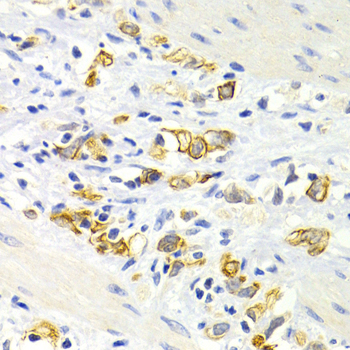
A2894: image 5

For quotations, please use our online quotation form, and you may also contact us by
sales@neoscientific.com
+1-888.733.6849
+1-617.299.7367 (Int’l)
+1-888.733.6849
+1-617.299.7367 (Int’l)
| Reactivity | Human Mouse |
| Tested applications | WB IHC |
| Recommended Dilution | WB 1:500 - 1:1000 IHC 1:50 - 1:100 |
| Calculated MW | 48kDa |
| Observed MW | Refer to Figures |
| Immunogen | A synthetic peptide of human DRD4 |
| Storage Buffer | Store at -20℃. Avoid freeze / thaw cycles. Buffer: PBS with 0.02% sodium azide, 50% glycerol, pH7.3. |
| Synonym | D4DR; |

Western blot analysis of extracts of Mouse liver tissue, using DRD4 antibody.

Immunohistochemistry of paraffin-embedded human cervical cancer tissue using DRD4 antibody.
Immunohistochemistry of paraffin-embedded human metrocarcinoma using DRD4 antibody at dilution of 1:200 (400x lens).

Immunohistochemistry of paraffin-embedded mouse kidney using DRD4 antibody at dilution of 1:200 (400x lens).
Immunohistochemistry of paraffin-embedded human stomach cancer using DRD4 antibody at dilution of 1:200 (400x lens).
This gene encodes the D4 subtype of the dopamine receptor. The D4 subtype is a G-protein coupled receptor which inhibits adenylyl cyclase. It is a target for drugs which treat schizophrenia and Parkinson disease. Mutations in this gene have been associated with various behavioral phenotypes, including autonomic nervous system dysfunction, attention deficit/hyperactivity disorder, and the personality trait of novelty seeking. This gene contains a polymorphic number (2-10 copies) of tandem 48 nt repeats; the sequence shown contains four repeats.
N/A